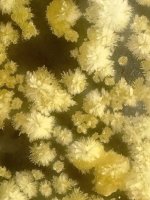
IMG_0950.jpeg IMG_0950.jpeg
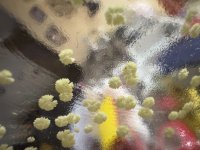
IMG_0917.jpeg IMG_0917.jpeg

Chronicuser
Esteemed member
Long time lurker. Just want to say how much I love and appreciate this site more than my words could ever convey.
Just wanted to post my first MHRB extraction, I used jurmea purple and followed cybs hybrid ATB ‘salt’ tek to the letter on my first two 50g runs, and my last 50g run I used filtered water in place of distilled water. I re-x all 3 times with varying results.
* First run





*second





*Final







Just wanted to post my first MHRB extraction, I used jurmea purple and followed cybs hybrid ATB ‘salt’ tek to the letter on my first two 50g runs, and my last 50g run I used filtered water in place of distilled water. I re-x all 3 times with varying results.
* First run





*second





*Final